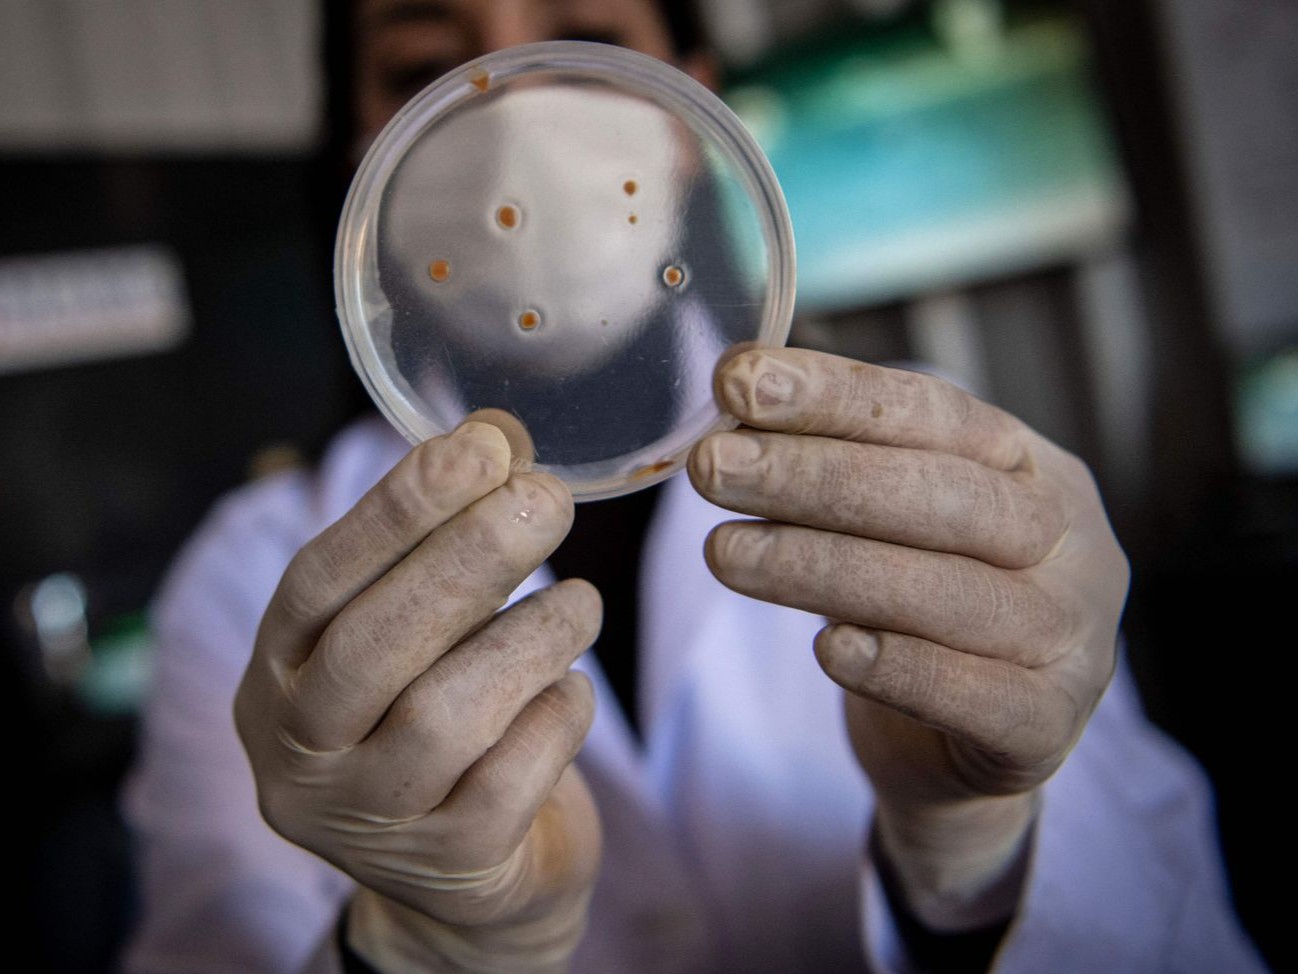
article image

اكتشف باحثون في بريطانيا آلية جديدة تفسر مقاومة بعض البكتيريا للمضادات الحيوية الشائعة، وهو ما يمهد الطريق لتطوير علاجات أكثر فعالية ضد العدوى البكتيرية التي يصعب علاجها.
وأكد الباحثون أن استهداف هذه الآلية الدفاعية يمكن أن يساعد في مواجهة خطر مقاومة مضادات الميكروبات، التي تعد واحدة من أخطر التحديات الصحية في العالم حالياً.
كشفت الدراسة، التي أجراها علماء من جامعة إدنبرة البريطانية، أن بعض أنواع البكتيريا تمتلك نظاماً خاصاً لإصلاح الحمض النووي الريبي (RNA) التالف داخلها، وهو ما يسمح لها بمواصلة إنتاج البروتينات الضرورية للنمو والبقاء حتى في وجود المضادات الحيوية التي تهدف أصلاً إلى تعطيل هذه العملية الحيوية.
وأوضح الباحثون أن هذا النظام الإصلاحي، المعروف باسم "RTC" يشكل هدفاً دوائياً جديداً يمكن أن يستغل في تحسين فاعلية المضادات الحيوية الحالية وإعادة قدرتها على القضاء على البكتيريا المقاومة.
قدرة على الالتفات
أظهرت الدراسة أن المضادات الحيوية تعمل عادة عبر استهداف إنتاج البروتينات الأساسية داخل الخلايا البكتيرية، وهي الخطوة التي تقود إلى توقف نموها وموتها. غير أن وجود نظام "RTC" داخل بعض السلالات البكتيرية يمنحها قدرة استثنائية على التعافي من الأضرار التي تحدثها هذه الأدوية، فعندما تتعرض البكتيريا لمضاد حيوي يعيق عمل الريبوسومات المسؤولة عن ترجمة المعلومات الوراثية من الحمض النووي إلى بروتينات، يتدخل هذا النظام لإصلاح جزيئات الحمض النووي الريبي التالفة، ما يسمح للخلايا بمواصلة نشاطها الحيوي رغم العلاج.
أكد الباحثون أن هذه القدرة على "الالتفاف" حول آلية الدواء تمثل أحد الأسباب التي تجعل بعض أنواع العدوى البكتيرية مستعصية على العلاج، رغم استخدام مضادات حيوية قوية أو متعددة الأنواع.
وبينت التحاليل أن تفاعل البكتيريا مع المضادات الحيوية ليس متجانسا دائماً، إذ تختلف درجة تعبيرها عن نظام "RTC" من خلية إلى أخرى، ما يجعل بعض الخلايا أكثر قدرة على البقاء من غيرها، وتظهر هذه الفوارق داخل تجمع البكتيريا نفسه سبب فشل العلاجات في القضاء الكامل على العدوى، إذ يمكن أن تنجو خلايا قليلة لتعيد نشر المقاومة من جديد بعد انتهاء العلاج.
استخدم فريق الباحثين مزيجاً من النماذج الحاسوبية المتقدمة والتجارب المعملية الدقيقة لفهم هذه الظاهرة، واعتمدوا على بكتيريا الإشريكية القولونية كنموذج تجريبي، وهي واحدة من أكثر الأنواع شهرة في قدرتها على تطوير مقاومة متعددة للمضادات الحيوية، ومن خلال مراقبة نشاط الخلايا في ظروف خاضعة للرقابة، تمكن الفريق من تحديد الدور المحوري الذي يلعبه نظام "RTC" في تعزيز بقاء الخلايا تحت ضغط العلاج الدوائي.
أظهرت النتائج أن كبح نشاط هذا النظام أو تعطيله يجعل البكتيريا أكثر حساسية للمضادات الحيوية، إذ تصبح غير قادرة على إصلاح جزيئاتها الحيوية بعد الضرر.
واستنتج الباحثون أن تطوير أدوية تستهدف هذا النظام مباشرة ربما يعيد فعالية المضادات الحيوية الموجودة بالفعل، ويجعلها أكثر قدرة على القضاء على العدوى المقاومة.
أكدت الدراسة أن هذا الاكتشاف لا يقدم فقط تفسيراً جديداً لمقاومة البكتيريا، بل يفتح الباب أمام استراتيجيات علاجية مبتكرة، إذ يمكن استغلال نقاط الضعف في نظام الإصلاح البكتيري لإنتاج مركبات دوائية تعطل عمله، ما يضعف قدرة البكتيريا على البقاء، ويجعلها عرضة للقتل بواسطة المضادات التقليدية.
وقال الباحثون إن هذه المقاربة المزدوجة - أي الجمع بين مضاد حيوي تقليدي ودواء يستهدف آلية الإصلاح - ربما تشكل خطوة حاسمة في كبح تصاعد أزمة المقاومة الدوائية عالمياً.
بارعة في التعلم
أشار الباحثون إلى أن المقاومة المتزايدة للمضادات الحيوية تعد من أخطر التهديدات الصحية في القرن الحادي والعشرين، إذ تؤدي إلى فشل العلاجات المعروفة وارتفاع معدلات الوفيات؛ بسبب العدوى البسيطة التي كانت قابلة للعلاج في الماضي، وتظهر التقديرات الدولية أن مقاومة مضادات الميكروبات تتسبب في وفاة مئات الآلاف سنوياً، مع توقعات بأن يصل العدد إلى ملايين الحالات بحلول منتصف القرن إذا لم يتم تطوير أدوية جديدة، ومن هذا المنطلق، يمثل فهم الآليات الجزيئية التي تمنح البكتيريا قدرة البقاء خطوة مركزية في معركة الطب الحديث ضد هذه الظاهرة.
قالت المؤلفة المشاركة في الدراسة، أندريا فايس، من كلية العلوم البيولوجية وكلية المعلوماتية بجامعة إدنبرة أن البكتيريا "مخلوقات بارعة في التعلم"، موضحة أن هذه الكائنات البسيطة طورت على مدار العقود وسائل ذكية للتكيف مع الأدوية المصممة لقتلها، وهي تتحسن باستمرار في هذا المجال.
وأضافت أن ما يحاول العلماء فعله الآن هو كشف أسرار هذه الأنظمة الدفاعية الخفية، حتى يمكن تجاوزها بخطط علاجية أكثر ذكاء، وأكدت أن رؤية الآلية بوضوح تتيح للباحثين تصميم طرق جديدة لتجاوزها وعلاج العدوى بفعالية أكبر.
اعتمدت الدراسة على تحليل تفصيلي لبنية نظام "RTC" ووظائفه داخل الخلايا البكتيرية، وتبين أن هذا النظام يتألف من مجموعة من البروتينات الإنزيمية التي تعمل معا لإصلاح أضرار الحمض النووي الريبي، سواء كانت ناجمة عن ضغط بيئي أو عن هجوم دوائي. وتعمل هذه الإنزيما عبر تحديد مواقع الضرر وقطع الأجزاء المتضررة ثم إعادة وصلها بعد الإصلاح، في عملية دقيقة تضمن استمرار الترجمة الوراثية دون انقطاع، ومن خلال المحاكاة الحاسوبية، تمكن الفريق من رسم خريطة ثلاثية الأبعاد لتفاعلات هذه البروتينات، ما أتاح تحديد النقاط التي يمكن أن تستهدف بالأدوية.
كشف الباحثون أن استجابة نظام "RTC" ليست موحدة بين جميع أنواع البكتيريا، إذ تختلف في قوتها وتنشيطها وفق نوع السلالة والبيئة التي تعيش فيها، ففي بعض الأنواع، يفعل النظام بسرعة عالية بمجرد التعرض للمضاد الحيوي، بينما يظل في أنواع أخرى في حالة خمول نسبي.
ويشير هذا التباين إلى أن تصميم الأدوية الجديدة يجب أن يأخذ في الاعتبار هذه الفروق الدقيقة لضمان تحقيق أعلى فاعلية ممكنة ضد مجموعة واسعة من الميكروبات.
فهم مقاومة البكتيريا
اعتمد فريق البحث على بيانات جرى جمعها من أكثر من مختبر متخصص، بما في ذلك مختبرات في جامعة كوين ماري وجامعة إمبريال كوليدج في لندن، حيث ساهم العلماء في تطوير النماذج الرياضية وتحليل نتائج التجارب المعملية. وساهمت مؤسسات بحثية كبرى في تمويل المشروع، منها مجلس أبحاث التكنولوجيا الحيوية والعلوم البيولوجية في المملكة المتحدة، ومؤسسة ليفرهولم تراست، ومؤسسة ويلكم الطبية.
اعتبر الباحثون أن النتائج تمثل خطوة علمية بارزة في فهم مقاومة البكتيريا، لأنها تركز على آلية لم تكن معروفة من قبل، موضحين أن معظم الجهود السابقة كانت تركز على دراسة الجينات التي تمنح البكتيريا مقاومة مباشرة للمضادات، مثل إنتاج الإنزيما التي تعطل الدواء أو تعديل مستقبلاته، لكن هذه الدراسة تسلط الضوء على مستوى أعمق، حيث تظهر كيف تستطيع الخلايا إصلاح أضرارها الداخلية بدلا من مجرد الدفاع عن نفسها من الخارج.
ورجح العلماء أن يؤدي هذا الفهم الجديد إلى إعادة النظر في تصنيف بعض السلالات البكتيرية من حيث قابليتها للعلاج، لأن وجود نظام "RTC" النشط فيها قد يكون مؤشراً على مقاومة محتملة للعقاقير، حتى لو لم تظهر الجينات التقليدية للمقاومة، كما يمكن أن تستخدم هذه المعرفة لتطوير اختبارات تشخيصية جديدة تكتشف وجود النظام في العدوى مبكراً، ما يتيح للطبيب اختيار العلاج الأنسب لكل حالة على حدة.
ولفت الباحثون إلى أن استخدام النماذج الحاسوبية كان محورياً في هذا التقدم العلمي، إذ أتاح محاكاة سلوك البكتيريا تحت تأثير الأدوية على مستوى الجزيئات والذرات، وهو ما يصعب تحقيقه تجريبياً في المختبرات، وسمح هذا الدمج بين علم الأحياء الحاسوبي والتجارب المخبرية بفهم شامل للعمليات الديناميكية التي تجري داخل الخلية البكتيرية عند تعرضها للمضاد الحيوي.
ليست مجرد كائنات بدائية
ورأى فريق البحث أن هذا النهج متعدد التخصصات يمثل مستقبل أبحاث مقاومة الميكروبات، لأن الجمع بين الذكاء الاصطناعي والمحاكاة الرياضية والبيولوجيا الجزيئية يمكن أن يسرع اكتشاف أهداف دوائية جديدة ويقلل الزمن اللازم لتطوير أدوية فعالة، مشددين على أن التعاون بين الجامعات والمؤسسات البحثية يمثل نموذجاً لما يجب أن يكون عليه العمل العلمي في مواجهة التحديات الصحية العالمية المعقدة.
واعتبر الباحثون أن هذه النتائج تبرهن على أن البكتيريا ليست مجرد كائنات بدائية، بل أنظمة معقدة قادرة على التكيف بسرعة مدهشة مع الظروف المعاكسة، لافتين إلى أن نجاحها في تطوير دفاعات متعددة ضد الأدوية البشرية يفرض على العلماء التفكير خارج الأطر التقليدية والبحث عن حلول مبتكرة تتعامل مع البكتيريا كخصم متطور لا كعدو بسيط.